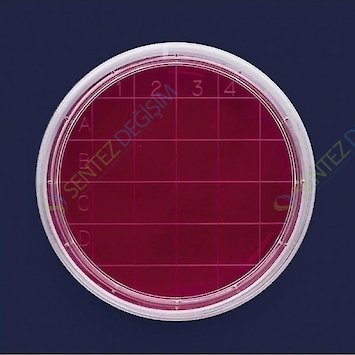
ISOLAB 081.04.060 Petri Kutusu Rodak - 60 mm - Steril A

Ürün Kodu
SD.IS.081.04.060
Ürün Markası
ISOLAB PLASTİK PETRİ KUTUSU ISOLAB Plastik Petri Kutuları; Deri, çalışma tezgahları, ve diğer tüm yüzeylerdeki bakteriyolojik konteminasyon testlerinde kullanılmak üzere son derece şeffaf polistirenden üretilirler. Aynı zamanda koloni sayımıda yapılabilir.
| Ambalaj | : 500 Adet |